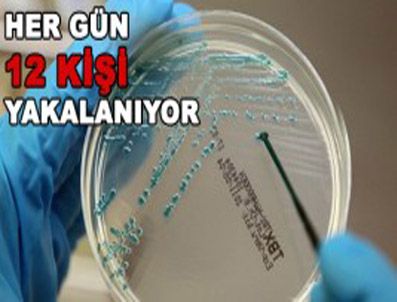
Ölü sayısı 16'e yükseldi

Haber Arşivi
Nato‘dan El Kaide Operasyonu
NATO, El Kaide terör örgütünün öldürülen lideri Usame bin Ladin‘in yardımcısı ve örgütün üst düzey bir yetkilisinin Afganistan‘ın kuzeyinde yakalandığını bildirdi.
2 Haziran 2011 Perşembe 11:21:21Yaralı Polisin Tedavisi Sürüyor
Rize Sağlık Müdürü Mustafa Tepe, Artvin‘in Hopa ilçesinde Başbakan Recep Tayyip Erdoğan‘ın konvoyuna yapılan taşlı saldırı sırasında yaralanan polis memuru Servet Erkan‘ın durumuyla ilgili net bir şey söylemek için uyandırılmasını bekleyeceklerini söyledi.
2 Haziran 2011 Perşembe 11:19:29"Abba The Show" İstanbul‘a Geliyor
Bir zamanların efsane grubu ABBA‘nın eski elemanlarının bir araya gelerek yeniden canlandırdıkları unutulmaz performansları, "Abba The Show" 8 Haziran‘da Cemil Topuzlu Açıkhava Sahnesi‘nde sanatseverlerle buluşacak.
2 Haziran 2011 Perşembe 11:17:52'Bulunduğum yer için yaratılmışım'
Popüler Türk Müziği yorumcusu Ahmet Özhan, çocukluğunda meşhur olacağını emin olarak hissettiğini belirterek, "Ben bulunduğum yer için yaratılmışım" dedi.
2 Haziran 2011 Perşembe 11:22:05Ölü sayısı 16'e yükseldi
ALMANYA'DA yüzlerce insana bulaşan, ardından İsveç, Hollanda, İngiltere, Fransa, Danimarka ve Avusturya'da da görülen EHEC bakterisi can almaya devam ediyor.
2 Haziran 2011 Perşembe 11:21:46Kepez‘in Çılgın Projesi: Kepez Park Varsak‘ta Tam Olimpik Yüzme Havuzu
Antalya Kepez Belediye Başkanı Hakan Tütüncü, Varsak’ta yapmayı planladıkları çılgın projeyi açıkladı. ‘Kepez Park Varsak’ adı verilen ve 47 dönümlük alana yapılması planlanan projede, sinema salonları, tam olimpik yüzme havuzları, sosyal alanlar ve spor alanları yer alacak.
2 Haziran 2011 Perşembe 11:18:38Adana Geleceği İçin Birlik Oldu
Adana Büyükşehir Belediyesi’nce düzenlenen ve kentin tüm dinamiklerinin katıldığı “Adana’nın Geleceği Stratejileri Çalıştayı”, çalışma gruplarının, sorunların tespiti ve çözüm önerileri görüşmeleri ile tamamlandı.
2 Haziran 2011 Perşembe 11:19:13Bitlis Gezici Sinema Ve Tiyatro Aracına Kavuştu
Bitlis Valisi Nurettin Yılmaz, Mahsun Kırmızıgül‘ün hem yazdığı hem de oynadığı film olan ‘New York‘ta Beş Minare‘ filminin galasını salon olmadığı için Bitlis‘te yapamadıklarına çok üzüldükleri hatırlatarak "Artık sinema sistemimiz hazır" dedi.
2 Haziran 2011 Perşembe 11:03:00Ahlat Polis Dinlenme Tesisi Hizmete Açıldı
Bitlis‘in Ahlat İlçe Emniyet Müdürlüğü tarafından Van Gölü sahilinde açılan ve çalışanların moral ve motivasyonlarını artırmayı amaçlayan dinlenme tesisi hizmete açıldı.
2 Haziran 2011 Perşembe 11:04:00Ak Parti Van Milletvekili Adayı Kayatürk‘ün Seçim Çalışmaları
Adalet ve Kalkınma Partisi (AK Parti) Van milletvekili adayı Burhan Kayatürk, hazırlayacakları projelerle kendilerine taş atan çocukları topluma kazandıracaklarını söyledi.
2 Haziran 2011 Perşembe 11:05:00Mamaklı Öğrencilere Çok Amaçlı Yaz Okulu
Mamak Belediyesi, öğrencilerin tatili eğitici ve eğlenceli bir şekilde geçirmelerini sağlamak çok amaçlı yaz okulunu açıyor.
2 Haziran 2011 Perşembe 11:08:00Kardeş Okul Öğrencileri Buluştu
Erzurum’da Sabancı İlköğretim Okulu öğretmenlerinden Semra Samancı tarafından yürütülen ‘Kardeş okul projesi kapsamında, kent merkezindeki iki ilköğretimi okulu öğrencileri, sinemada ilk kez 3 boyutlu film izleme imkanı buldu. Üç boyutlu gözlükleriyle filmi izleyen öğrenciler, patlamış mısırlarını yiyerek filmin keyfini çıkardı.
2 Haziran 2011 Perşembe 11:09:00Gazikent Üniversitesi 7. Tübitak-Ekual Yıllık Toplantısı‘na Katıldı
Gazikent Üniversitesi Kütüphane ve Dokümantasyon Müdürü Mustafa Cesur; Antalya‘da gerçekleşen 7. TÜBİTAK-EKUAL yıllık toplantısına katıldı.
2 Haziran 2011 Perşembe 11:09:00Alabalık Diyarbakırlıların Ağız Tadı Oldu
Diyarbakır ve yöresinde had safhaya ulaşan Alabalık üretme çiftlikleri yetiştirdikleri balıklarla vatandaşların damak tadına hitap etmeye başladı.
2 Haziran 2011 Perşembe 11:11:00Dyp‘den Ak Parti‘ye Geçiş
Doğru Yol Partisi (DYP) Kilis 1. sıra Milletvekili Adayı Ejder Savtur partisinden istifa ederek AK Parti‘ye geçti. Savtur‘un rozetini AK Partili Hüseyin Çelik taktı.
2 Haziran 2011 Perşembe 11:13:00Diksad Konserine Yoğun İlgi
Didim Kültür ve Sanat Derneği (DİKSAD) ücretsiz Türk Sanat Müziği konseri düzenledi. Konsere Didimliler büyük ilgi gösterdi.
2 Haziran 2011 Perşembe 11:13:00Trabzon’Da İlköğretim Okulu Öğrencilerine Sağlıklı Beslenme Ve Kişisel Hijyen Konusunda Eğ
Trabzon Özel Yıldızlı Güven Hastanesi tarafından ilköğretim okulu öğrencilerine yönelik genel hijyen ve beslenme konusunda eğitim verildi.
2 Haziran 2011 Perşembe 11:14:0080 Darbesi Öncesi Kandırıldıklarını Belirten Tkp‘li: Artık Oyunlara Gelmeyiz
12 Eylül 1980 darbesi öncesi, kandırılarak birbirlerine sağcı-solcu diye düşürüldüklerini belirten dönemin Türkiye Komünist Partisi(TKP) üyesi Şemsettin Hamzaçebi(57), bugün artık oynanan oyunların farkında olduklarını ve aynı oyuna gelmeyeceklerini söyledi.
2 Haziran 2011 Perşembe 11:12:16Numan Kurtulmuş: Düşmanlık diliyle siyaset yapılmamalı
Has Parti Genel Başkanı Numan Kurtulmuş, Türkiye'de düşmanlık diliyle siyaset yapıldığını belirterek, "Siyasi partiler olarak biz birbirimizin düşmanı değiliz, rakipleriz.
2 Haziran 2011 Perşembe 11:13:17Yağmur Koleji, Kitap Okumada Birinci Oldu
Cumhurbaşkanı Abdullah Gül’ün başlatmış olduğu ‘Türkiye Okuyor’ kampanyası doğrultusunda Şırnak Valiliği ile il milli eğitim müdürlüğünün düzenlediği Kitap Dostu Proje Yarışması’nda Şırnak Özel Burç Yağmur Koleji 4.sınıf öğrencisi Şirin Doru, birinci oldu.
2 Haziran 2011 Perşembe 11:14:19Oğuzeli’Nin İlk Sosyal Tesisi Açıldı
Gaziantep’in merkez ilçesi Oğuzeli ilk sosyal tesisine kavuştu. Oğuzeli Belediye Başkanı Bekir Öztekin’in girişimleri ve MB Holding’in sponsorluğunda yapılan sosyal tesise ”Selman–Ayşe Fatma Balat” ismi verildi.
2 Haziran 2011 Perşembe 11:15:22Paris Hilton: 'Herkes beni fahişe gibi görüyor'
Paris Hilton kötü kız imajının sebebini açıkladı
2 Haziran 2011 Perşembe 11:14:40Expo 2020 İçin Sağlık Zirvesi
İzmir Ticaret Odası, sağlık temasıyla EXPO 2020‘ye aday olan İzmir‘in temasının geliştirilmesi amacıyla Sağlık Zirvesi düzenledi.
2 Haziran 2011 Perşembe 11:02:00Minibüste 62 Bin Paket Kaçak Sigara Ele Geçirildi
Van‘ın Erciş İlçe Emniyet Müdürlüğü ekipleri tarafından bir minibüste yapılan aramada, 62 bin paket kaçak sigara ele geçirildi.
2 Haziran 2011 Perşembe 11:00:00Minibüs Dehşeti Güvenlik Kamerasında
Güngören‘de, kontrolden çıkan bir yolcu minibüsü, bir araca çarptıktan sonra yol kenarındaki bir giyim mağazasına daldı. Minibüsteki 3 yolcunun yaralandığı kaza, yol üzerindeki bir güvenlik kamerası tarafından saniye saniye kaydedildi.
2 Haziran 2011 Perşembe 11:04:00